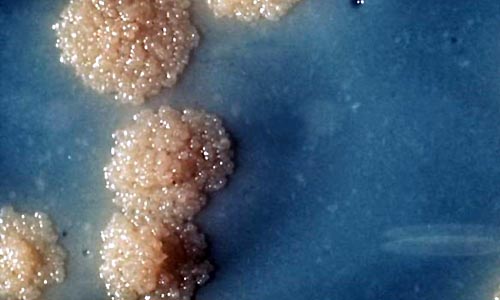

De acordo com confirmações feitas pelo Centro de Controle e Prevenção de Doenças (CDC), dos EUA, no Havaí, seis homens e uma mulher contraíram uma forma de gonorreia altamente resistente.
Os sete pacientes eventualmente conseguiram ser tratados a partir de uma combinação de medicamentos potentes – o que não é usual no caso de tratamentos comuns. No entanto, testes de laboratórios mostraram que a estirpe da bactéria não sucumbiu facilmente aos antibióticos. Agora, os especialistas temem que este tipo de infecção intratável possa se tornar mais comum do que se imaginava, segundo informações do Daily Mail.
Desde 2005, foram relatados apenas quatro casos isolados que apresentaram resistência aos medicamentes comumente utilizados para tratar a infecção – a ceftriaxona e azitromicina. No entanto, este é o primeiro conjunto de casos que apresentaram susceptibilidade reduzida a ambas as drogas.
O relatório do CDC foi divulgado na última quarta-feira. Apesar de anos de avisos de que as bactérias estavam construindo resistência a uma série de antibióticos, os cientistas advertiram que ninguém estava fazendo nada para atrasar ou parar o processo. O relatório revelou que hospitais não limitaram prescrições desta classe de medicamentos e que, na verdade, o uso de antibióticos nos últimos anos havia aumentado.
Estima-se que, atualmente, a resistência das bactérias aos medicamente tire 700.000 vidas por ano. Autoridades globais de saúde pública ainda alertaram que este número pode subir para 10 milhões por ano até 2050, se o uso de antibióticos não for limitado.
Segundo eles, a culpa por trás deste desastre em potencial está relacionada ao uso negligente de antibióticos no tratamento de doenças menores e em animais. Administrar pequenas doses desta classe de medicamento no corpo permite que as bactérias possam se adaptar à droga, construindo defesas contra ela. Como resultado disso, infecções comuns, como a gonorreia e E. coli, em breve serão consideradas intratáveis.
“A resistência dessas DSTs para o efeito de antibióticos tem aumentado rapidamente nos últimos anos e reduziu as opções de tratamento”, disse a ONU. A mesma resistência foi observada em casos de clamídia e sífilis, embora de forma menos comum.
A gonorreia também já apresentou imunidade a penicilina, tetraciclina e a classe das fluoroquinolonas. Quando não diagnosticada, as três doenças podem trazer consequências graves. Em mulheres, por exemplo, aumenta as chances de gravidez ectópica, aborto, morte fetal e neonatal.

Comments